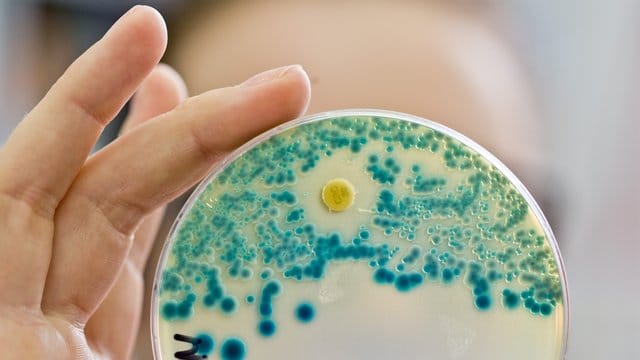

Trotz resistenter Keime NDR: Pharmakonzerne entwickeln keine neuen Antibiotika mehr
Hamburg (dpa) - Immer mehr Pharmahersteller ziehen sich nach Informationen des NDR aus der Erforschung neuer Antibiotika zurück.
Fast die Hälfte der etwa 100 Firmen, die 2016 eine gemeinsame Erklärung über mehr Anstrengungen im Kampf gegen Resistenzen vereinbart hatten, sei in dem Bereich nicht mehr aktiv, berichtet der Fernsehsender am Donnerstag in der Sendung "Panorama" im Ersten (21.15 Uhr).
Der Internationale Pharmaverband (IFPMA) hatte damals eine Industrieallianz gegründet. Neue Antibiotika werden benötigt, weil Bakterien zunehmen gegen ältere resistent werden.
Grund für den Rückzug der Unternehmen sind laut NDR die geringeren Verdienstmöglichkeiten im Vergleich zu Medikamenten gegen Krebs und chronische Erkrankungen. Sie werden nur wenigen Tage eingenommen. Zudem sollten neue Mittel nur im Notfall eingesetzt werden, wenn alle herkömmlichen Antibiotika nicht mehr anschlagen.
Der deutsche Verband Forschender Arzneimittelhersteller (VFA) ist der Ansicht, dass es insgesamt zu wenig Forschungsprojekte in gibt. Die Aktivitäten stagnierten auf zu niedrigem Niveau, sagte der Geschäftsführer Forschung, Siegfried Throm, der Deutschen Presse-Agentur. Antibiotika-Resistenzen seien weltweit ein großes Problem.
Aufgrund der besseren Versorgung und Hygiene könnten in Deutschland allerdings bis zu 90 Prozent aller Patienten mit den vorhandenen Mitteln gut behandelt werden. Pro Jahr gebe es rund 3300 Todesfälle infolge von Antibiotika-Resistenzen, sagte Trohm unter Berufung auf Zahlen des Europäischen Zentrums für die Prävention und die Kontrolle von Krankheiten (ECDC). In anderen Ländern seien die Zahlen sehr viel höher.
Die Politik müsste auf internationaler Ebene die Entwicklung neuer Mittel stärker fördern. Im Bereich der präklinischen Forschung funktioniere das schon gut, sagte Trohm. Besonders teuer sei aber die spätere Entwicklung von den klinischen Versuchen bis zur Marktzulassung.